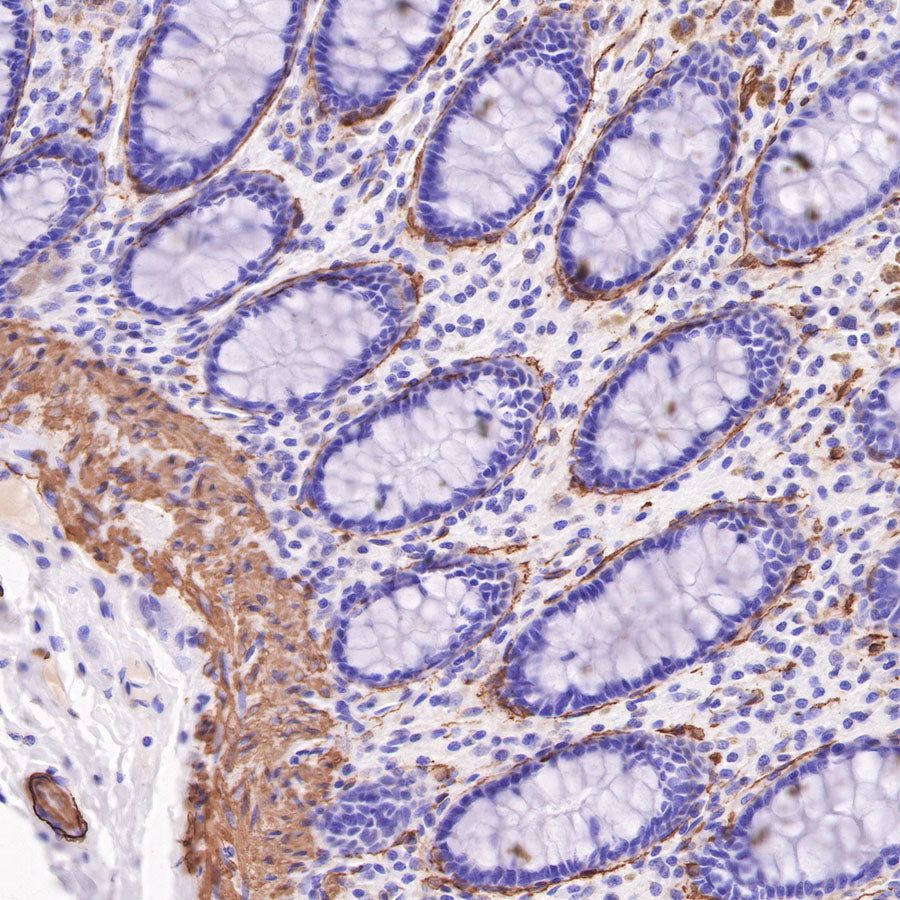
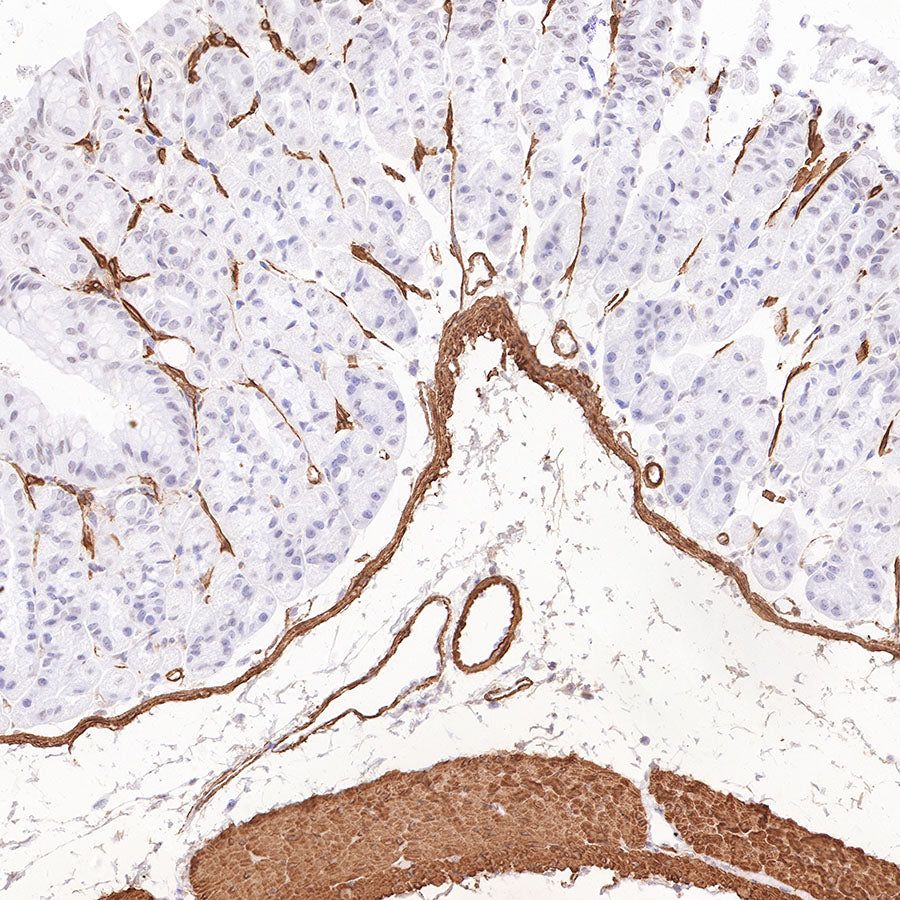
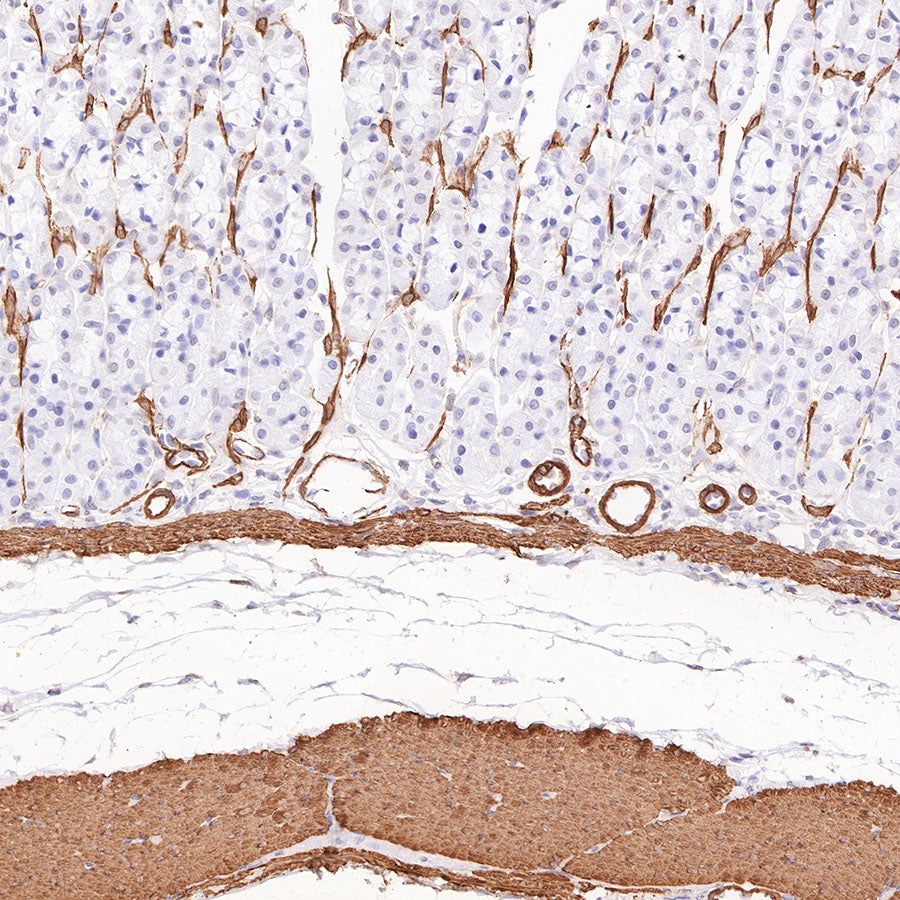

Product Specification
| Host |
Mouse |
| Antigen |
ALPHA SMOOTH MUSCLE ACTIN |
| Synonyms |
Alpha-actin-2, ACTA2, SMA |
| Immunogen |
N/A |
| Location |
Cytoplasm, Cytoskeleton |
| Accession |
P62736 |
| Clone Number |
SDT-R142 |
| Antibody Type |
Recombinant mAb |
| Isotype |
IgG2a |
| Application |
WB, IHC-P, ICC, ICFCM, IP |
| Reactivity |
Hu, Ms, Rt |
| Purification |
Protein A |
| Concentration |
0.4 mg/ml |
| Tag |
N/A |
| Physical Appearance |
Liquid |
| Storage Buffer |
PBS, 40% Glycerol, 0.05% BSA, 0.03% Proclin 300 |
| Stability & Storage |
12 months from date of receipt / reconstitution, -20 °C as supplied |
Dilution
| application |
dilution |
species |
| WB |
1:1000-1:4000 |
null |
| IHC-P |
1:4000 |
null |
| ICC |
1:100 |
null |
| ICFCM |
1:400 |
null |
| IP |
1:40 |
null |
Background
α-smooth muscle actin, encoded by ACTA2, is expressed in abundance in vascular smooth muscle, comprising 50–70% of total actin, with the remainder composed of β-cytoplasmic and γ-actins. Whereas α-smooth muscle expression is normally restricted to smooth muscle cells, it can also be expressed in nonmuscle cells, most notably myofibroblasts that use cell traction forces to remodel extracellular matrix.